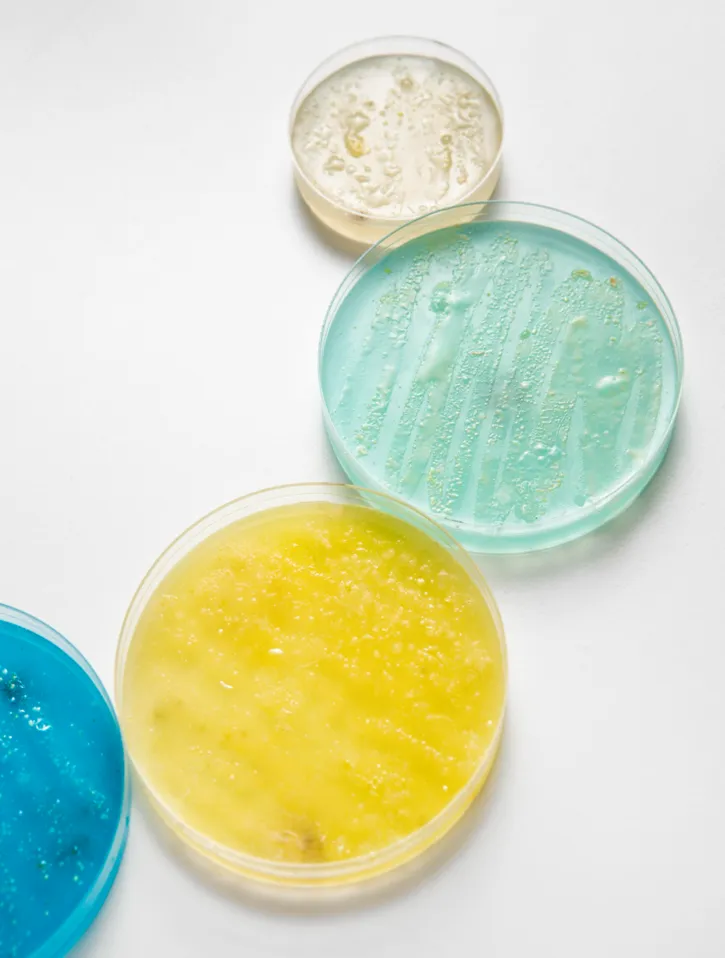
Kozmetik Kimyasalları

Kozmetik Kimyasalları
AROMA KİMYASALLARI
- C-11 Undesilenik Aldehit
- Undesilenik Asit
- Kalsiyum Undesilenik
- Çinko Undesilenik
- Heptaldehit
- Alfa Amyl Cinnamic Aldehit
- Heptanoik Asit
- Stiren Oksit
- Difenil Oksit
- Alfa Kamfolenik Aldehit
- Fenil Etil Alkol
- Stiralil Asetat
- Fenil Etil Metil Eter

DOĞAL EKSTRATLAR & ESANSİYEL YAĞLAR
- Aloe Ekstrat
- Hamamelis Ekstrat
- Butcher’s Broom Ekstrat
- Cornflower Ekstrat
- Kırmızı Biber Oleorezini
- Karabiber Oleorezini
- Guarana Ekstrat
- Amazon yağları
- Argan yağı
- Hindistan cevizi yağı
- Soya fasulyesi yağı
- Ayçiçeği tohumu yağı
- Keten tohumu yağı
- Macadamia tohumu yağı
- Monoi yağı
- Zeytin meyvesi yağı
- Pirinç kepeği yağı
- Avokado yağı
- Kayısı çekirdeği yağı
- Hint yağı
- Buğday özü yağı

YUMUŞATICILAR
- Kaprilik/Kaprik Trigliserit
- C12-15 Alkil Benzoat
- Setil Palmitat
- Coco-Kaprilat/Kaprat
- Dikaprilil Eter
- Etilhekzil Kokoat
- Etilhekzil Palmitat
- Etilhekzil Stearat
- Isonil İzononanoat
- Izopropil Miristat
- Izopropil Palmitat
- Izopropil Izostearat
- Izostearyl Neopentanoat
- Miristil Miristat
- Kandelilla Wax
- Karnauba Wax
- Mikrokristalin Wax
- Doğal ve Sentetik Balmumu
- Mineral Yağlar
- Parafinler
- Petrolalüm
KOZMETİK & DETERJAN KİMYASALLARI
- Sodyum Lauril Eter Sülfat 70%
- Trietanolamin Lauril Eter Sulfat
- Amonyum Lauril Eter Sulfat 70%
- Amonyum Lauril Eter Sulfat 30%
- Hindistan Cevizi Yağ Asitleri
- Kokamidopropil Betain
- Kokamidopropil Hidroksisültain
- Kokamidopropil Dimetil Amin Oksit
- Disodyum Laureth Sulfosüksinat
- Alkil Dimetil Amin Oksit
- Maleik Akrilik Kopolimer
- Etilen Glikol
- n-Alkil Dimetil Benzil Amonyum Klorür
- Polietilen Glikol Gliseril Kokoat
- Sodyum Ksilen Sülfonat
- Rafine Gliserin

EMÜLGATÖRLER & ÇÖZÜNÜRLEŞTİRİCİLER & YÜZEY AKTİF MADDELER
- Laurik Asit
- Miristik Asit
- Oleik Asit
- Palmitik Asit
- Stearin Asit
- Stearin
- Kaprilik Asit
- Setearil Alkol
- Setil Alkol
- Lauril ve Miristil Alkol
- Miristil Alkol
- Oleil Alkol
- Stearil Alkol
- Polisorbat Serileri
- Sorbitan Laurat
- Sorbitan Oleat
- Sorbitan Palmitat
- Sorbitan Stearat

- Gliseril Stearat Sitrat
- PEG-6 Kaprilik/Kaprik Gliseritler
- PEG-7 Gliseril Kokoat
- Sorbitan Olivat
- Gliseril
- Setearat Serileri
- Setet Serileri
- Setoleth Serileri
- Laureth Serileri
- Oleth Serileri
- Steareth Serileri
- Amfoterikler
- Anyonikler
- Katyonikler
- Non Iyonikler (Alkil Poliglikozitler)
- Kaprilil/ Kapril Glukozit
- Coco Glukozit
- Lauril Glukozit
- PEG-Cocoat Serileri
- PEG-Oleat Serileri
- PEG-Stearat Serileri
- Ester Karışımları
- Izopropil Miristat
- PEG-40
- PEG-60
FİLM OLUŞTURUCU POLİMERLER & NEM TUTUCULAR & MODİFİYE EDİCİLER
- PVP (K30)
- PVP (K30L)
- PVP (K90)
- PVP/VA Kopolimer
- Butilen Glikol
- Gliserin
- Propilen Glikol
- Sorbitol
- Kandelilla Wax
- Karnauba Wax
- Guar Gum
- Ksantan Gum
- Akrilatlar
- Karbomer
- Parafinler


SİLİKONLAR & KORUYUCULAR & GÜÇLENDİRİCİLER
- Amodimediconlar
- Kopolimerler
- Dimedicon Akışkanlar
- Gum Karışımları
- Fenil Modifiye Silikon
- Silikon kopolyoeller
- Uçucu Akışkanlar
- Benzoik Asit
- Klorheksidin Diglukonat 20%
- Paraben
- Fenoksietanol
- Potasyum Sorbat
- Sodyum Benzoat
- Kaprilil Glikot
- Etilhekzil Gliserin
- Propanediol

AKTİFLER & EKSFOLİYANLAR
- Alantoin
- Amino Asitler
- Kafein
- Hiyalüronik Asit
- Pirokton Olamin
- Sakkarin
- Titanyum Dioksit
- Çinko Oksit
- Glukono-Delta-Lakton
- Glikolik Asit 70%
- Laktik Asit
- Malik Asit
- Salisilik Asit
- Traneksamik Asit
- Sitrik Asit
ÇÖZÜCÜLER
- Etanol (Denatüre Alkol)
- Izopropil Alkol (IPA)
- Dipropilen Glikol (DPG)
- Propilen Glikol (PG)
- Trietil Sitrat
- Benzil Benzoat
- Dietil Ftalat (DEP)
- Izopropil Miristat (IPM)
- Kaprilik/Kaprik Trigliseit
- Bütilen Glikol
- Polysorbat 20 / 80 (Tween)
- Benzil Alkol
- Dietil Flalat (DEP)
- Heksilem Glikol
- Siklopentasiloksan
- Etilhekzil Gliaerin
- Dimetikon
- Metilpropanediol (MPD)
- Transcutol (Dietilen Glikol Monoetil Eter)
- Propilen Karbonat

ORGANİK ÜRÜNLER



- Coriolus Versicolor / Turkey Tail (Toz, Ekstrakt)
- Schisandra (Toz, Ekstrakt)
- Sibirya Ginsengi (Toz, Ekstrakt)
- Balkabağı (Ekstrakt, Meyve Suyu Tozu)
- Withania Somnifera Ekstraktı
- Agaricus Bisporus / Beyaz Şapkalı Mantar (Toz, Ekstrakt)
- Pirinç Proteini Tozu
- Sarımsak (Toz, Ekstrakt)
- Arpa Çimi (Toz, Ekstrakt, Meyve Suyu Tozu)
- Agaricus Blazei Murrill (Toz, Ekstrakt)
- Klorella (Toz, Ekstrakt)
- Gözotu Bitkisi Ekstraktı
- Buğday Çimi (Toz, Ekstrakt, Meyve Suyu Tozu)
- Alıç (Toz, Ekstrakt)
- Yabani Yams Kökü (Toz, Ekstrakt)
- Açai Meyvesi (Toz, Ekstrakt)
- Kakao Tozu
- Hindistan Cevizi (Suyu Tozu, Süt Tozu)
- Yalancı İğde / Deniz İğdesi (Ekstrakt, Meyve Tozu)
- Yulaf (Toz, Ekstrakt)
- Maca Kökü (Toz, Ekstrakt)
- Dulavratotu (Kök Tozu, Ekstrakt)
- Kivi (Ekstrakt, Meyve Tozu, Meyve Suyu Tozu)
- Aslan Yelesi Mantarı / Hericium Erinaceus (Toz, Ekstrakt)
- Kuşburnu (Ekstrakt, Toz)
- Pancar Kökü (Toz, Ekstrakt)
- Zencefil (Meyve Suyu Tozu, Toz)
- Domates (Toz, Ekstrakt)
- Inonotus Obliquus / Chaga Mantarı (Toz, Ekstrakt)
- Tutku Meyvesi Tozu
- Nar (Ekstrakt, Toz, Meyve Tozu, Meyve Suyu Tozu)
- İstiridye Mantarı / Pleurotus Ostreatus (Toz, Ekstrakt)
- Matcha Çayı Ekstraktı
- Mürver (Ekstrakt, Toz)
- Kral İstiridye Mantarı / Pleurotus Eryngii (Toz, Ekstrakt)
- Goji Berry (Ekstrakt, Meyve Suyu Tozu, Toz)
- Limon (Toz, Ekstrakt)
- Pitaya / Ejder Meyvesi (Toz, Ekstrakt, Meyve Suyu Tozu)
- Maitake Mantarı / Grifola Frondosa (Toz, Ekstrakt)
- Reishi / Ganoderma Lucidum (Toz, Ekstrakt)
- Dut (Ekstrakt, Toz)
- Inülin Tozu
- Greyfurt (Ekstrakt, Toz)
- Ispanak (Toz, Ekstrakt)
- Ananas (Meyve Suyu Tozu, Meyve Tozu, Ekstrakt)
- Çemen Otu (Toz, Ekstrakt)
- Karahindiba (Toz, Ekstrakt)
- Yaban Mersini (Toz, Ekstrakt, Meyve Suyu Tozu)
- Siyah Frenk Üzümü (Toz, Ekstrakt)
- Siyah Fungus / Odun Mantarı (Ekstrakt, Toz)
- Mor Tatlı Patates (Toz, Ekstrakt)
- Siyah Çay (Ekstrakt, Toz)
- Yeşil Çay Ekstraktı
- Kara Lahana (Toz, Ekstrakt, Meyve Suyu Tozu)
- Tarçın (Toz, Ekstrakt)
- Havuç (Toz, Ekstrakt)
- Mango (Ekstrakt, Meyve Suyu Tozu, Meyve Tozu)
- Aloe Vera Ekstraktı
- Kereviz (Toz, Ekstrakt)
- Elma Sirkesi Tozu
- Poria Cocos / Tuckahoe Mantarı (Toz, Ekstrakt)
- Çilek (Toz, Ekstrakt, Meyve Suyu Tozu)
- Phellinus Linteus Mantarı (Toz, Ekstrakt)
- Nane (Toz, Ekstrakt)
- Spirulina (Toz, Ekstrakt, Tablet)
- Karpuz (Toz, Ekstrakt)
- Yaban Turnası Meyvesi (Cranberry) Ekstraktı
- Cordyceps Militaris Mantarı (Toz, Ekstrakt)
- Brokoli (Toz, Ekstrakt Tozu)
- Bezelye (Toz, Ekstrakt, Protein, Lif)
- Bilberry / Avrupa Yaban Mersini (Ekstrakt, Toz)
- Moringa (Toz, Ekstrakt)
- Enoki / İğne Mantarı (Toz, Ekstrakt)
